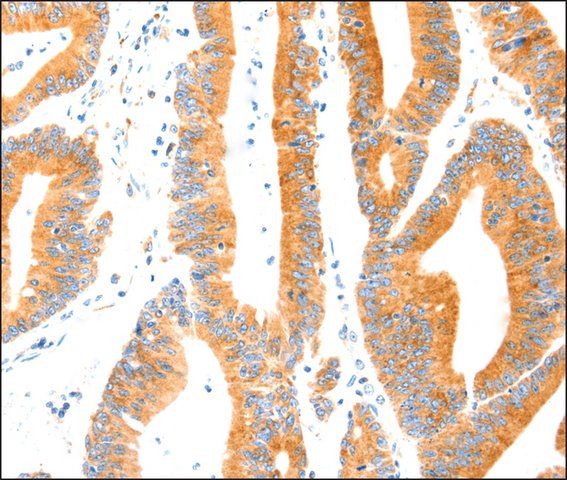

产品说明
特异性
The antibody detects endogenous levels of total MANF protein.
免疫原
Synthetic peptide corresponding to residues near the C terminal of human mesencephalic astrocyte-derived neurotrophic factor
特点和优势
Evaluate our antibodies with complete peace of mind. If the antibody does not perform in your application, we will issue a full credit or replacement antibody. Learn more.
外形
Rabbit IgG in pH7.3 PBS, 0.05% NaN3, 50% Glycerol.
免责声明
Unless otherwise stated in our catalog or other company documentation accompanying the product(s), our products are intended for research use only and are not to be used for any other purpose, which includes but is not limited to, unauthorized commercial uses, in vitro diagnostic uses, ex vivo or in vivo therapeutic uses or any type of consumption or application to humans or animals.
基本信息
| NACRES | NA.41 |
产品性质
| 生物来源 | rabbit |
| 质量水平 | 100 |
| 抗体形式 | affinity isolated antibody |
| antibody product type | primary antibodies |
| 克隆 | polyclonal |
| 形式 | buffered aqueous solution |
| species reactivity | mouse, human, rat |
| 浓度 | 2.5 mg/mL |
| technique(s) | immunohistochemistry: 1:100- 1:300 |
| 同位素/亚型 | IgG |
| 登记号 | NP_006001.4 |
| UniProt登记号 | P55145 |
| 运输 | wet ice |
| 储存温度 | −20℃ |
| Gene Information | human ... MANF(7873) |
安全信息
| 储存分类代码 | 10 - Combustible liquids |
| WGK | WGK 1 |
| 闪点(F) | Not applicable |
| 闪点(C) | Not applicable |